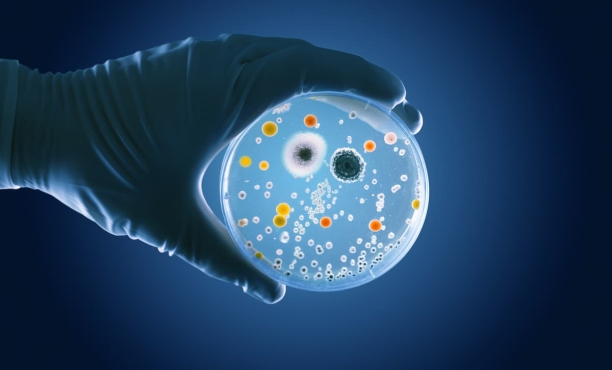
Микробиота: необходима для здоровья, но что мы знаем о ней?

Здоровый образ жизни
Микробиота: что мы о ней знаем?
Ipsos провел международное исследование “International Microbiota Observatory” для Института Микробиоты Biocodex. Полученные данные демонстрируют, что общество недостаточно хорошо осведомлено о вкладе микробиоты (или микрофлоры) в здоровье человека. Результаты исследования подчеркивают роль врачей в повышении осведомленности пациентов по этой теме.
1 - 9 of 13 items








